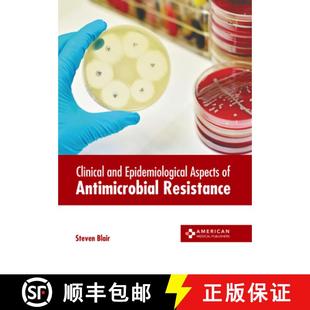

電腦版 |
網站地圖|
Sitemapxml|
淘寶網|
淘寶網|
天貓|
天貓|
淘寶|
寵物網|
CopyRight © 深圳市若懷信息科技有限公司 2020-2028 淘寶網
粵ICP備18038786號
介紹
- Epidemiological優惠專場,當前第1頁,實時更新高性價比Epidemiological單品、淘寶網Epidemiological打折特賣信息,全場低至1折起包郵,敬請關注!這些Epidemiological都是由本站為您精挑細選的,時下最好、最流行的,都是抖音,快手,小紅書,知乎等知名博主網紅推薦,歡迎進入頁面了解Epidemiological價格、Epidemiological圖片等相關信息!淘寶網致力于幫您節省瀏覽海量商品信息時間,讓您以更優惠的折扣價格購買到自己喜歡的Epidemiological!獲得Epidemiological淘寶優惠券及天貓優惠券,請點此搜索->【Epidemiological】的優惠券。
商品分類
熱門搜索
- Epidemiological
- 中國黃金男士項鏈
- 電動車配件大全
- 華為路由器旗艦店官方旗艦
- 媽媽皮涼鞋
- 口罩定制印logo
- 籃球鞋男款秋冬
- 劉海梳
- 55°c杯子
- 眼鏡框男款
- 生日禮物女生一周耳釘套裝
- 音箱電腦臺式
- 粉色內褲
- 香云紗兩件套
- 新中式小吊燈
- 手撕面包整箱旗艦店
- 剎車油更換機
- 進口護膚面膜
- 男內褲 跨境歐美
- 自動卷發棒電動旋轉大波浪
- 文件包手提袋
- 睡裙女冬 連帽
- 兒童棉拖鞋2022新款冬天包跟
- 電動牙刷架 壁掛式
- 浴巾大人純棉
- 雅詩蘭黛小棕瓶套裝
- 男包 胸包
- 打包紙箱 28*12*6
- 小包 女 包包 斜挎包
- 女童裙子秋冬兩件套
- 衛生間瓷磚縫隙防水填縫劑
- 芳凱爾面膜
- 阿迪長褲
- 塑料叉車托盤
- 門口鞋柜
- 下衣失蹤t恤女 韓版 學生 寬松
- 女套裝 兩件套 洋氣